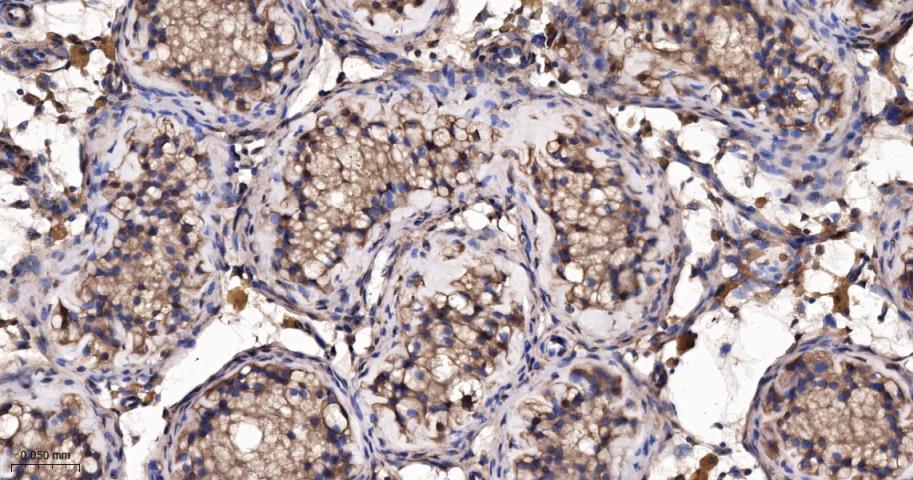
热休克蛋白56重组兔单抗

热休克蛋白56重组兔单抗
Rrmab?兔单抗

货号:bsm-60690R
产品详情
相关标记
相关产品
相关文献
常见问题
概述
产品编号
bsm-60690R
产品类型
重组兔单抗
英文名称
FKBP52 Recombinant Rabbit mAb
中文名称
热休克蛋白56重组兔单抗
英文别名
FKBP51; FKBP52; FKBP59; HBI; Hsp56; PPIase; p52; FKBP-4; FKBP-52; FKPB52; p59; FKBP4_HUMAN; FKBP4; PPIase FKBP4; 51 kDa FK506-binding protein (FKBP51); 52 kDa FK506-binding protein (52 kDa FKBP | FKBP-52); 59 kDa immunophilin (p59); FK506-binding protein 4 (FKBP-4); HSP-binding immunophilin (HBI); Immunophilin FKBP52; Rotamase; 5.2.1.8; FKBP4_MOUSE; FKBP4_RAT;
抗体来源
Rabbit
免疫原
KLH conjugated synthetic peptide derived from human FKBP52
亚型
IgG
性状
Liquid
纯化方法
affinity purified by Protein A
克隆类型
Recombinant
克隆号
R1A10
理论分子量
52 kDa
浓度
1mg/ml
储存液
0.01M TBS (pH7.4) with 1% BSA, 0.02% Proclin300 and 50% Glycerol.
SWISS
Gene ID
保存条件
Shipped at 4℃. Store at -20℃ for one year. Avoid repeated freeze/thaw cycles.
注意事项
This product as supplied is intended for research use only, not for use in human, therapeutic or diagnostic applications.
数据库链接
产品介绍
有研究表明;FKBP52蛋白可能防止Tau蛋白的过度磷酸化,FKBP52可控制致病性Tau蛋白的异常产生。当AD患者的神经细胞FKBP52水平降低时,致病性Tau蛋白将不会沉积,将不能促进脑细胞的变性,FKBP52蛋白是迄今为止发现的唯一一个有抗Tau蛋白特性的蛋白。FKBP52蛋白能降低阿尔茨海默氏症患者大脑中致病性Tau蛋白的产生。
背景资料
The protein encoded by this gene is a member of the immunophilin protein family, which play a role in immunoregulation and basic cellular processes involving protein folding and trafficking. This encoded protein is a cis-trans prolyl isomerase that binds to the immunosuppressants FK506 and rapamycin. It has high structural and functional similarity to FK506-binding protein 1A (FKBP1A), but unlike FKBP1A, this protein does not have immunosuppressant activity when complexed with FK506. It interacts with interferon regulatory factor-4 and plays an important role in immunoregulatory gene expression in B and T lymphocytes. This encoded protein is known to associate with phytanoyl-CoA alpha-hydroxylase. It can also associate with two heat shock proteins (hsp90 and hsp70) and thus may play a role in the intracellular trafficking of hetero-oligomeric forms of the steroid hormone receptors. This protein correlates strongly with adeno-associated virus type 2 vectors (AAV) resulting in a significant increase in AAV-mediated transgene expression in human cell lines. Thus this encoded protein is thought to have important implications for the optimal use of AAV vectors in human gene therapy. The human genome contains several non-transcribed pseudogenes similar to this gene. [provided by RefSeq, Sep 2008]

产品应用
| 应用 | 已检合格种属 | 预测种属 | 推荐稀释比例 |
|---|---|---|---|
| WB | Human, Mouse, Rat | 1:500-2000 | |
| IHC-P | Human, Mouse, Rat | 1:100-500 | |
| IHC-F | Human, Mouse, Rat | 1:100-500 | |
| IF | Human, Mouse, Rat | 1:100-500 | |
| Flow-Cyt | Human, Mouse, Rat | 1:50-100 | |
| ICC/IF | Human, Mouse, Rat | 1:50-200 |
交叉反应
交叉反应: Human, Mouse, Rat
相关产品
暂无相关产品
靶标
基因名
FKBP4
蛋白名
Peptidyl-prolyl cis-trans isomerase FKBP4
亚基
Homodimer. Associates with HSP90 and HSP70 in unactivated steroid hormone receptor complexes. Also interacts with peroxisomal phytanoyl-CoA alpha-hydroxylase (PHYH). Interacts with HSF1 in the HSP90 complex. Associates with tubulin (By similarity). Interacts with MAPT/TAU (By similarity). Interacts with NR3C1 and dynein (By similarity). Interacts (via TPR domain) with S100A1, S100A2 and S100A6; the interaction is Ca(2+) dependent. Interaction with S100A1 and S100A2 (but not with S100A6) leads to inhibition of FKBP4-HSP90 interaction.
亚细胞定位
Cytoplasm; cytosol. Nucleus. Cytoplasm; cytoskeleton.
组织特异性
Widely expressed.
翻译后修饰
Phosphorylation by CK2 results in loss of HSP90 binding activity (By similarity).
相似性
Contains 2 PPIase FKBP-type domains.
Contains 3 TPR repeats.
功能
Immunophilin protein with PPIase and co-chaperone activities (By similarity). Component of unliganded steroid receptors heterocomplexes through interaction with heat-shock protein 90 (HSP90). May play a role in the intracellular trafficking of heterooligomeric forms of steroid hormone receptors between cytoplasm and nuclear compartments (By similarity). The isomerase activity controls neuronal growth cones via regulation of TRPC1 channel opening. Acts also as a regulator of microtubule dynamics by inhibiting MAPT/TAU ability to promote microtubule assembly.
标记抗体
暂无标记数据
同靶标产品
暂无同靶标产品
相关文献
提示: 发表研究结果有使用 bsm-60690R 时请让我们知道,以便我们可以引用参考文章。作为回馈,资料提供者将获得我们送上的小礼品。
暂无相关文献
常见问题
暂无常见问题